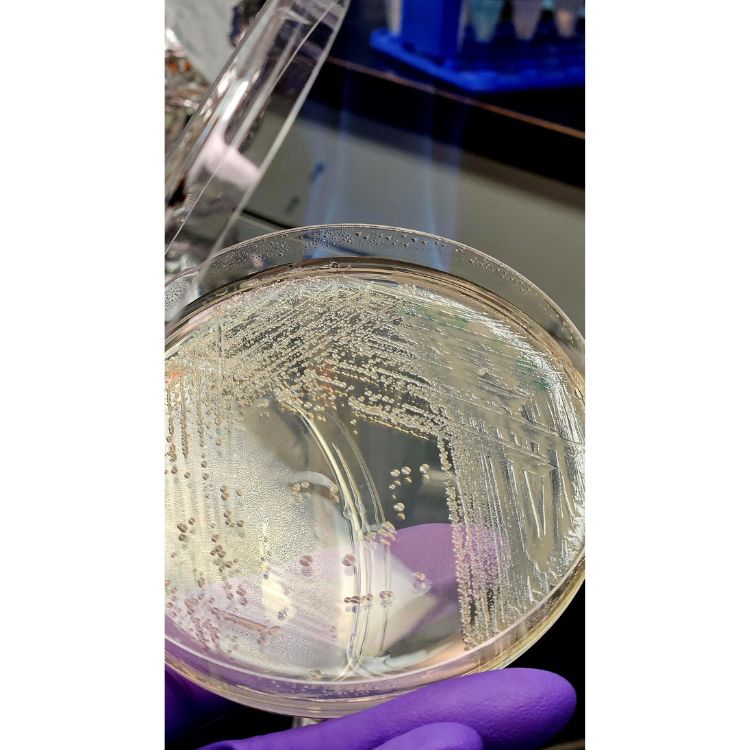

University Bridge | a SciArt Space
| Welcome to University Bridge | a SciArt Space, a showcase of art reflecting science and medicine. |
| Shining a light on each other's blind spots, both science and art seek to comprehend, appreciate, and elucidate the world we live in through inquiry, often incorporating different cultural perspectives. |
| Invoking our local Saskatoon monument, University Bridge | a Sciart space offers a concise exploration of a Sciartist’s work by an artist, a scientist, and writer to inform our readers of the opportunities and benefits of bridging the talents of artists, scientists and other interested communities. |
2025 OVDR Cover Art Competition
Sarah Ha

Sarah Ha, "A Breath of Life Science". Second Year Master's of Anatomy, Physiology and Pharmacology. 2025.
Taylor Dzikowski

Taylor Dizowski, "The Rainbow Microtissue". Second Year Master's Student in Health Sciences. 2025.
Ananna Arna

Arshdeep Jagait

Valiyah Khurshid

Alyssa Anand

Alyssa Anand, "Abstract Medicine". First Year Medical Student. 2025.
Mehrdad Askarian, Gary Groot, Tracey Carr

Nooshin Shekari

Sundus Zia

Anum Ali

Anum Ali, "Always on the Road". First Year Medical Resident. 2025
Kayla Cropper

Krishna Daida

Krishna Daida, “Zebrafish” and "Hippocampal Mossy Cell”. 5th Year Undergrad Student in Cellular Physiological and Pharmacological Sciences, 2025.
Breanne Bevelander

Annita Velasque

Annita Velasque, "Inside Job", ObGyn Resident, 2025.
Hamza Saghir
2024 OVDR Cover Art Competition

Jae Newton, “Wings Over Boreal Waters”. Fourth Year MD Student. 2024.

Mahesh Rachamalla, "Mandala abstract: Multigenerational impacts of arsenic in fish", PhD candidate, 2024.


"The Prairie Scientist" by Mason Bealiu

Retaj Ramadan, "Carpal Tunnel Release". 4th Year MD Student. 2024.

Richard Ngo, "Synaptic Harmony". Resident Physician, Swift Current Family Medicine Program, 2024.

Romaisa Ismaeel, "Blazing Forests." Medical Student. 2024

"Tongue Anatomy" by Savio Nguyen

"Hereditary Spherocytosis" by Savio Nguyen

Shang (Selina) Shi, “Finding the way”. Resident, Diagnostic Radiology. 2024.
“I have got a lot on my plate right now!” by Shreoshri Bhattacharjee, Phd, Biochemistry, Microbiology & Immunology Department (BMI), 2024



Sukhman Kaur, “The Stories that Nature Shares”. MD Student, Year 1. 2024.

Sumayya Imran, "The Falls". MD Student, College of Medicine. 2024.
Participate
The goal of the showcase is to open the local reader who is ideally a local burgeoning scientist or artist to the opportunities that crossdisciplinarity practices can achieve\offer and the benefits to both artists, scientists and their communities.
Please send expressions of interest to OVDR Email. The Curatorial Committee will then communicate further instructions.
What are your thoughts on the interaction of science & art? How do they inform each other?